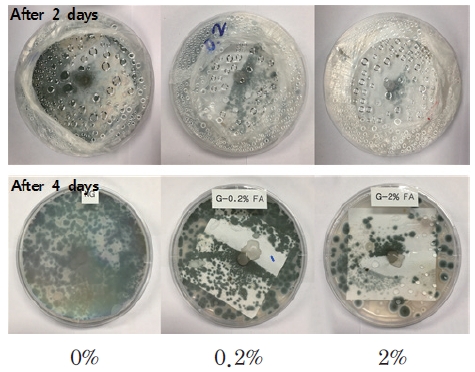
https://cdn.apub.kr/journalsite/sites/ktappi/2019-051-01/N0460510101/images/JKTAPPI_2019_v51n1_5_f012.jpg

1. 서 론
박물관 및 도서관 등에 보관된 주요 기록문서들은 널리 알려진 바와 같이 높은 온도 및 습도 등의 환경에서 열화가 촉진된다. 또한 균류, 박테리아, 해충 등에 의한 생물 열화, 빛에 의한 광산화, 공기 및 대기오염가스 등에 의해 산화 열화 등이 발생하기도 한다.1) 따라서 중요한 기록물을 보관하는 서고에서는 보존에 악영향을 끼치는 요소들을 최대한 제거하여 바람직한 환경 조성이 유지되도록 노력하고 있다. 균 및 부후균 등 생물학적 인자들은 고습도에 노출될 경우 단시간 내에 종이 기록물에 심각한 손상을 초래할 수 있다. 미생물은 종이에 침투하여 종이의 변색을 발생시키거나 종이 셀룰로오스 섬유를 분해 시킴으로써 결국은 종이기록물에 치명적인 손상을 입히게 되는 것이다. 종이를 열화시키는 미생물 중 가장 많은 비중을 차지하는 균류는 Aspergilli (약 30%)와 Penicilli(30% 이상)이며 곰팡이가 번식할 때에는 종이기록물의 기질인 셀룰로오스뿐만 아니라 제본 재료인 단백질을 분해하는데 단백질이 고갈될 경우 이들은 포자를 형성하여 공기와 같은 수단을 통해 새로운 근거지를 찾는다.2) 새 포자의 번식은 환경 통제가 이루어지지 않는 도서관의 경우에 전면적인 감염을 야기할 수 있다.
이러한 피해를 줄이기 위한 방안의 하나로 습도를 통제하는 방법이 있지만, 최적의 상대습도를 찾는 것은 어려운 일이다. 상대습도는 일정한 온도 내에서 공기에 포함되어 있는 수증기 최대량의 비율이며, 50%의 상대습도를 유지하는 환경에서의 기록물은 약 7%의 수분을 내포하는 데 비해, 상대습도가 70%일 경우에는 10%의 수분을 함유한다. 습도가 낮으면 종이에 부서짐이 발생하여 어느 정도의 상대습도는 종이의 유연성 유지에 필수적이다. 하지만 습도가 높으면 곰팡이 균에게는 유리한 환경이 되기 때문에 기록물의 보존을 위한 최대 상대습도는 65-70%이지만 이 범위 또한 곰팡이의 성장 위험이 크기 때문에 적절하지는 않다. 거기에 각기 다른 기록물들의 조건에 따른 최적의 상대습도를 찾기란 매우 어려운 일이다.
따라서 소수성을 지니는 기록용지를 제조할 경우 습도에 의한 영향을 감소시킬 수 있을 것으로 기대된다.
현재 우리나라의 경우 보존용지에 대한 표준규격(KS 규격)은 종이의 pH, 알칼리 함량, 리그닌 함량을 규정3)하고 있으며, 선진국의 경우에도 주로 종이의 pH, 알칼리 함량, 리그닌 함량, 강도 등에 대한 항목이 포함되어 있으나 내수성에 대한 기준은 국내외 모두 없는 실정이다. 현재까지 기록용지에 대한 연구는 보존환경(온습도, 자외선, 공기오염물질 등의 공기질) 및 미생물들에 의한 기록용지들의 열화인자 및 기작을 탐색하기 위한 연구 사례들에 제한되어 있고, 습해 및 수해에 대한 기록용지들의 열화기작에 대한 연구들은 거의 전무하며, 내수성 기록용지에 대한 연구는 이루어진 바가 없다. 따라서 습해 및 수해를 방지할 수 있는 기록보존용지에 대한 연구가 시급한 실정이다.
소수성을 부여하는 방법으로 로진-알럼, AKD(alkyl ketene dimer), ASA(alkenyl succinic anhydride)와 같은 사이즈제들의 내첨 및 외첨처리에 의한 연구가 진행되었으나,4-10) 내수성 및 발수성에 한계가 있다. 또한 발수 및 방오성을 부여하기 위한 대표적인 방법으로 PE(polyethylene) 라미네이팅,4) 실리콘 코팅 등의 후가공 처리가 주를 이루고 있으나 재활용이 어렵고 생분해되지 않기 때문에 환경 친화적인 면에서 문제점을 지니고 있다.
최근 들어 기상 그라프팅 기술을 적용하여 셀룰로오스를 소수화하는 기술에 대한 연구가 발표11-14)된 바 있으며, 이 기술을 이용하여 이형지, 포장지, 유류 흡착포, 온도 이력 센서15) 등을 개발하는 연구가 진행된 바 있으나 소수성 기록용지에 대한 연구 사례는 없다.
이에 본 연구에서는 palmitoyl chloride를 이용한 기상 그라프팅 소수화 반응으로 소수성 인쇄용지를 제조하고 이들의 소수성 기록용지로서의 이용가능성을 탐색하고자 하였다. 이를 위해 palmitoyl chloride의 농도를 변화시켜 인쇄용지의 소수성, 인쇄적성, 물리적 특성, 내곰팡이성 등을 비교분석하였다.
2. 재료 및 방법
2.1 공시 재료
2.1.1 인쇄용지
기상 그라프팅 처리를 위한 인쇄용지 시료는 평량 80 g/m2의 국내 H 사의 시판용 A4용지를 구입하여 사용하였으며 인쇄용지의 특성은 Table 1과 같다.
Table 1.
General properties of printing paper
| Items | Value |
|---|
| Basis weight (g/m2) | 80.00 |
| Thickness (μm) | 85.70 |
| Tensile strength MD (N·m/g) | 57.50 |
| Optical property | Brightness (%) | 85.72 |
| Whiteness (%) | 80.63 |
| Air resistance (s.) | 29.52 |
2.1.2 약품
기상 그라프트 반응을 위하여 palmitoyl chloride(CH3(CH2)14COCl)와 petroleum ether를 Sigma Aldrich에서 구입하여 추가 정제하지 않고 그대로 사용하였다.
2.1.3 공시균
기상 그라프팅 처리 유무에 따른 기록 용지의 생물학적 인공열화 특성 분석을 위한 공시균으로 조선왕조실록 밀랍본의 열화된 부분에서 분리한 Penicillium polonicum을 국립문화재연구소에서 분양받아 사용하였으며, PDA(Difco, USA) 배지에 접종하여 28℃에서 5일간 배양하였다.
2.2 실험방법
2.2.1 Palmitoyl chloride 기상 그라프트 처리
소수성 인쇄용지를 제조하기 위해 palmitoyl chloride 농도를 변화시켜 인쇄용지의 기상 그라프팅 처리를 실시하였으며, 자세한 처리 조건은 Table 2에 나타내었다.
Table 2.
Conditions of gas grafting treatment
| Conditions | Contents |
|---|
| Concentration of palmitoyl chloride soln. (%) | 0, 0.2, 2 |
| Reaction temperature (℃) | 150 |
| Reaction time (min) | 5 |
2.2.2 소수성 평가
각 인쇄용지의 소수성을 평가하기 위해 Cobb size 값을 TAPPI 441 om-13을 적용하여 항온·항습조건(온도 23.0±1.0℃, 관계습도 50.1±2%)에서 측정하였다. 먼저 25 cm2 크기의 Cobb size tester에 물 50 mL를 넣고 30분 동안 흡습된 물의 양을 측정한 후, Eq. 1에 따라 Cobb size 값을 계산하였다.
W°: weight of paper before wetting,
W: weight of paper after wetting.
2.2.3 물리적 특성
기상 그라프팅 처리가 인쇄용지의 강도에 미치는 영향을 평가하기 위해 ISO 187에 따라 상대습도 50±2%, 온도 23±1℃로 조절된 항온·항습실에서 24시간 이상 조습처리한 후, 각 인쇄용지 시료의 인장강도(L&W Tensile tester, Sweden) 및 파열강도(L&W Bursting strength tester, Sweden)를 각각 TAPPI Test Methods 494 om-88과 TAPPI Test Methods 403 om-02에 따라 측정하였다.
2.2.4 광학적 특성
기상 그라프팅 처리가 인쇄용지의 광학적 특성에 미치는 영향을 평가하기 위해 Elrepho spectrophotometer(L&W)를 이용하여 백색도(TAPPI Test Methods 1216 sp-03)와 색도(TAPPI Test Methods 1215 sp-03)를 측정하였다.
2.2.5 인쇄적성 평가
기상 그라프팅 처리가 인쇄용지의 인쇄 특성에 미치는 영향을 평가하기 위해 ink set-off 및 잉크젯 인쇄특성을 측정하였다. 먼저 RI printability tester(RI-Ⅱ, KRK, Japan)를 사용하여 종이 시료에 cyan 잉크를 0.5 g 전이시킨 후 ink set-off 인쇄특성을 평가하였다. 또한 종이의 잉크 흡수 특성 차이를 알아보기 위하여 각 종이 시료에 표준 색 테이블인 GAFT test form을 수용성 잉크로 인쇄한 뒤 육안으로 관찰하였다.
2.2.6 흡습율 평가
기상 그라프팅 처리가 고습도 조건에 노출 시 인쇄용지의 흡습율에 미치는 영향을 평가하기 위해 각 인쇄용지 시료를 80-90% RH 항온항습 챔버에서 4시간 동안 방치한 후 종이 시료의 무게를 측정하고, 이후 23℃,50% RH 조건에서 24시간 동안 조습처리한 후의 무게를 측정한 뒤 기건 함수율을 측정하여 기상 그라프팅 처리 조건에 따른 인쇄용지 시료의 흡습율을 비교분석하였다.
2.2.7 내곰팡이성 평가
기상 그라프팅 처리가 인쇄용지의 생물학적 열화 특성에 미치는 영향을 평가하기 위해 각 인쇄용지 시료의 Penicillium polonicum 균에 의한 생물학적 열화 시험을 실시하였다(Fig. 1.). 생물학적 열화 시험을 위해 먼저 소수화 정도가 다른 각 인쇄용지 시료를 각각 60×60 mm 사이즈로 재단한 후, 가압멸균장치(autoclave)에서 121℃로 80분간 멸균하였다. 이후 항온항습 챔버에 멸균된 종이 시료를 넣고 23℃, 80-90% RH 조건에서 4시간 동안 방치시킨 직후, 무균상자(clean bench) 내에서 직경 90 mm의 petri dish에 넣고 PDA 배지에 배양한 Penicillium polonicum 균을 cork borer(3호, φ6 mm)를 이용하여 절취한 후 종이 시료의 중앙에 접종하여 뚜껑을 닫아 para film으로 잘 밀봉하였다. 이후 28℃의 인큐베이터에서 2, 4일 동안 배양한 후 균의 생장특성을 육안으로 관찰하였다.

Fig. 1.
Biological aging test.
3. 결과 및 고찰
3.1 소수성
기상 그라프팅 처리 시 palmitoyl chloride 농도에 따른 인쇄용지의 소수성을 평가하기 위해 Cobb size 값을 측정한 결과를 Fig. 2에 나타내었다. Fig. 2에서 보는 바와 같이 기상 그라프팅 처리에 의해 인쇄용지의 Cobb size 값이 감소되었으며, palmitoyl chloride 농도가 높은 인쇄용지 시료의 Cobb size 값이 보다 감소되는 것으로 나타났다. Cobb size 값은 일정시간 동안 1 m2의 종이 시료가 흡수하는 물의 양을 측정한 값으로 종이의 소수성이 증가할수록 Cobb size 값이 감소하므로 기상 그라프팅 처리를 통한 소수성 인쇄용지 제조가 가능하다고 볼 수 있다. 특히 palmitoyl chloride 농도 조절을 통해 다양한 소수성을 가지는 기록용지 제조가 가능할 것으로 판단된다.

Fig. 2.
Effects of palmitoyl chloride concentration on the Cobb size value.
3.2 물리적 특성
기상 그라프팅 처리가 인쇄용지의 인쇄 특성에 미치는 영향을 평가하기 위해 처리 시 palmitoyl chloride 농도에 따른 인쇄용지의 인장강도 및 파열강도를 측정한 결과를 Figs. 3과 4에 나타내었다. Fig. 3에서 보는 바와 같이 0.2% palmitoyl chloride 처리 시에는 인장강도에 커다란 변화가 없었으나 2% palmitoyl chloride 처리 시에는 인장강도가 소폭 감소되었다. 파열강도 변화 또한 인장강도의 경우와 마찬가지로 0.2% palmitoyl chloride 처리 시에는 파열강도 변화가 없었으나 2% palmitoyl chloride 처리 시에는 약간 감소되는 경향을 나타냈다. 이러한 결과로 적절한 처리 농도는 0.2%로 판단된다.

Fig. 3.
Effects of palmitoyl chloride concentration on the tensile index.

Fig. 4.
Effects of palmitoyl chloride concentration on the burst index.
3.3 광학적 특성
기상 그라프팅 처리가 인쇄용지의 광학적 특성에 미치는 영향을 평가하기 위해 처리 시 palmitoyl chloride 농도에 따른 인쇄용지의 백색도 및 색도를 측정한 결과를 Figs. 5-8에 나타내었다. 먼저 palmitoyl chloride 농도에 따른 백색도 변화를 분석한 결과, Fig. 5에서 보는 바와 같이 기상 그라프팅 처리에 의한 인쇄용지의 백색도 변화는 거의 발생되지 않았다. 반면 색도(colorness)인 L*, a*, b*값은 기상 그라프팅 처리에 의해 각각 다른 변화 경향을 나타냈다(Figs. 6-8). L*값은 백색도의 경우와 마찬가지로 기상 그라프팅 처리에 따른 변화를 나타내지 않았다. 반면 a*값은 0.2% palmitoyl chloride 처리 시에는 변화가 발생되지 않았으나 2% palmitoyl chloride 처리 시에는 소폭 감소되었으며, b*값은 a*값과 반대로 2% palmitoyl chloride 처리 시 소폭 증가되었으나, 그 변화는 미미하였다. 따라서 기상 그라프팅에 의한 인쇄용지의 광학적 특성변화는 거의 발생되지 않은 것으로 나타났다.

Fig. 5.
Effects of palmitoyl chloride concentration on the brightness.

Fig. 6.
Effects of palmitoyl chloride concentration on the L* value.

Fig. 7.
Effects of palmitoyl chloride concentration on the a* value.

Fig. 8.
Effects of palmitoyl chloride concentration on the b* value.
3.4 인쇄 특성
기상 그라프팅 처리가 인쇄용지의 인쇄 특성에 미치는 영향을 평가하기 위해 처리 시 palmitoyl chloride 농도에 따른 인쇄용지의 ink set-off 및 잉크젯 인쇄특성을 측정한 결과를 Figs. 9와 10에 나타내었다. Fig. 9에서 보는 바와 같이 ink set-off 이미지를 비교분석한 결과 그라프팅 처리에 의한 ink set-off 차이는 거의 발생되지 않았다. 또한 잉크젯 인쇄특성을 분석하기 위해 GAFT test form 인쇄 이미지를 비교분석한 결과 ink set-off의 경우와 마찬가지로 기상 그라프팅 처리에 따른 변화를 거의 나타내지 않았다(Fig. 10). 이러한 결과로 볼 때 기상 그라프팅 처리가 인쇄용지의 인쇄특성에는 영향을 미치지 않는 것으로 판단된다.

Fig. 9.
Effects of palmitoyl chloride concentration on the ink set-off property.

Fig. 10.
Effects of palmitoyl chloride concentration on the aqueous ink printability.
3.5 흡습율
기상 그라프팅 처리가 인쇄용지의 흡습율에 미치는 영향을 평가하기 위해 처리 시 palmitoyl chloride 농도에 따른 인쇄용지의 흡수율을 측정한 결과를 Fig. 11에 나타내었다. Fig. 11에서 보는 바와 같이 기상 그라프팅 처리한 인쇄용지 즉, 소수성 인쇄용지의 상대습도 80%와 90%에서 흡습율이 감소되었으며, palmitoyl chloride 농도가 증가함에 따라 흡습율이 보다 감소되었다. 이러한 결과로 볼 때 고습도 노출 시 발생 가능한 컬 등의 물리적 변형이나 미생물 번식 등의 생물학적 열화가 감소될 것으로 기대된다.

Fig. 11.
Effects of palmitoyl chloride concentration on the moisture absorption content at different relative humidity. 0% 0.2% 2%
3.6 내곰팡이성 평가
기상 그라프팅 처리가 인쇄용지의 생물학적 열화 특성에 미치는 영향을 평가하기 위해 각 인쇄용지 시료의 Penicillium polonicum 균에 의한 생물학적 열화 시험을 실시한 후 균의 생장 특성을 이미지 분석한 결과를 Fig. 12에 나타내었다. Fig. 12에서 보는 바와 같이 기상 그라프팅 처리한 인쇄용지에서의 균 생장이 미처리 인쇄 용지에 비해 느린 것으로 나타났으며, 특히 palmitoyl chloride 농도가 높을수록 즉, 소수화 값이 높을수록 균생장이 억제되는 것으로 나타났다. 이는 기상 그라프팅 처리에 의한 흡습율 결과에 상응하는 결과로 수분은 상기 기술된 바와 같이 균의 생장에 꼭 필요한 인자로 고습 도에서의 노출 시 흡습율은 균 생장에 직접적으로 영향을 미칠 수 있다. 따라서 기상 그라프팅 처리를 통해 생물학적 열화를 방지할 수 있는 소수성 기록용지 제조가 가능할 것으로 판단된다.
Fig. 12.
Effects of palmitoyl chloride concentration on the biological aging characteristics.
4. 결 론
기상 그라프팅 소수화 반응을 이용한 소수성 인쇄용지 제조 시 palmitoyl chloride 농도가 인쇄용지의 소수성, 인쇄적성, 물리적 특성, 내곰팡이성 등에 미치는 영향을 평가한 결과 다음과 같은 결론을 얻을 수 있었다.
1. 기상 그라프팅 처리에 의해 소수성 인쇄용지 제조가 가능하였으며, 특히 palmitoyl chloride 농도를 조절하여 인쇄용지의 소수화 정도를 조절할 수 있었다.
2. 기상 그라프팅 처리 시 palmitoyl chloride 농도에 따른 인쇄용지의 강도적 특성, 광학적 특성, 인쇄 특성을 분석한 결과 강도적 및 광학적 특성의 경우 0.2% palmitoyl chloride 처리 시에는 인쇄용지의 강도적 특성, 광학적 특성, 인쇄 특성에 변화가 발생하지 않았으나, 2% palmitoyl chloride 처리 시 소폭 감소되는 경향을 나타내었다. 인쇄 특성의 경우에는 기상 그라프팅에 의한 변화가 거의 발생되지 않았다.
3. 기상 그라프팅 처리에 의해 제조된 소수성 인쇄용지의 고습도에서의 흡습율이 미처리 인쇄용지보다 낮았으며, 특히 palmitoyl chloride 농도가 높은 경우 즉, 높은 소수성을 가지는 인쇄용지의 흡습율 감소가 보다 현저하였다.
4. 고습도에서 수분을 흡습한 소수성 인쇄용지의 균 생장이 기상 그라프팅 처리하지 않은 인쇄용지 원지보다 느리게 나타나 생물학적 열화가 감쇠되었으며, palmitoyl chloride 농도가 높을 경우 즉, 소수성이 높은 인쇄용지의 생물열화 감쇠율이 보다 우수하였다.
따라서 palmitoyl chloride를 이용한 기상 그라프팅 처리를 통해 습해 및 이들로부터 파생되는 생물학적 피해를 더 크게 감소시킬 수 있는 소수성 기록용지를 제조할 수 있다고 판단된다.
Acknowledgements
이 논문은 2017년도 강원대학교 대학회계 학술연구조성비(관리번호-520170367)와 2018년도 정부(과학기술정보통신부)의 재원으로 한국연구재단의 지원(NRF-2018R1A2B2003646)을 받아 수행된 연구임.
Literature Cited
J. H. Jo, K. H. Choi, Y. S. Kang, J. H. Park, H. Y. Jung and K. D. Yun,
Comparison of aging characteristics of the duplicated beeswax-treated and non-treated paper books during humid heating agingProceedings of 2011 Fall Conference of the Korea TAPPI; 429-432 (2011)
Jo, J. H., Choi, K. H., Kang, Y. S., Park, J. H., Jung, H. Y., and Yun, K. D., Comparison of aging characteristics of the duplicated beeswax-treated and non-treated paper books during humid heating aging, Proceedings of 2011 Fall Conference of the Korea TAPPI, pp. 429-432 (2011).
J. H. Park, K. H. Choi and J. H. Seo, Journal of Korea TAPPI,
A study on growth of Aspergillus versicolor and Penicillium polonicum within the beeswax treated paper,
42(2); 20-26 (2010)
Park, J. H., Choi, K. H., and Seo, J. H., A study on growth of Aspergillus versicolor and Penicillium polonicum within the beeswax treated paper, Journal of Korea TAPPI 42(2):20-26 (2010).
Korea standard method,
Information and documentation-Archival, paper-Requirements for permanence and durability (2014)
KS M ISO 11108, Information and documentation-Archival, paper-Requirements for permanence and durability, Korea standard method (2014).
J. H. Lee, C. K. Kim, J. Y. Ryu and M. K. Lee,
Hydrophobization of paper surface by pilot scale gas grafting technologyProceedings of 2015 Spring Conference of the KSIEC; 24 (2015)
Lee, J. H., Kim, C. K., Ryu, J. Y., and Lee, M. K., Hydrophobization of paper surface by pilot scale gas grafting technology, Proceedings of 2015 Spring Conference of the KSIEC, p.24 (2015).
H. L. Lee, H. J. Youn, M. S. Seo, J. J. Lee and J. H. Shin,
Improvement of AKD sizing efficiency for linerboardProceedings of 2003 Autumn Conference of the Korea TAPPI; 363-370 (2003)
Lee, H. L., Youn, H. J., Seo, M. S., Lee, J. J., and Shin, J. H., Improvement of AKD sizing efficiency for linerboard, Proceedings of 2003 Autumn Conference of the Korea TAPPI, pp.363-370 (2003).
C. H. Kim and D. S. Shin, Journal of Korea TAPPI,
Studies on sizing development of ASA and strength properties of paper by DS of cationic starch and drying temperature of sheets,
26(1); 5-17 (1994)
Kim, C. H. and Shin, D. S., Studies on sizing development of ASA and strength properties of paper by DS of cationic starch and drying temperature of sheets, Journal of Korea TAPPI 26(1):5-17 (1994).
K. T. Hodgson, Appita Journal,
A review of paper sizing using alkyl ketene dimer versus alkenyl succinic anhydride,
47(5); 402-406 (1994)
Hodgson, K. T., A review of paper sizing using alkyl ketene dimer versus alkenyl succinic anhydride, Appita Journal 47(5):402-406 (1994).
A. Karademir, D. Hoyland, N. Wiseman and H. Xiao, Appita Journal,
A study of the effects of alkyl ketene dimer and ketone on paper sizing and friction properties,
57(2); 116-120 (2004)
Karademir, A., Hoyland, D., Wiseman, N., and Xiao, H., A study of the effects of alkyl ketene dimer and ketone on paper sizing and friction properties, Appita Journal 57(2):116-120 (2004).
A. G. Robert, US patent,
Modified filler material for alkaline paper and method of use thereof in alkaline paper making (1996)
Robert, A. G., Modified filler material for alkaline paper and method of use thereof in alkaline paper making, US patent, US5527430 A (1996).
M. Nishiyama, A. Isogai and F. Onabe, Journal of Society of Fiber Science and Technology,
Structures of alkenyl succinic anhydride (ASA) components in ASA-sized papersheet,
52(4); 180-188 (1996)
Nishiyama, M., Isogai, A., and Onabe, F., Structures of alkenyl succinic anhydride (ASA) components in ASA-sized papersheet, Journal of Society of Fiber Science and Technology 52(4):180-188 (1996).
10.2115/fiber.52.180D. Samain, Europe patent,
Method for treating a solid material to make it hydrophobic, material obtained and uses (1998)
Samain, D., Method for treating a solid material to make it hydrophobic, material obtained and uses, Europe patent, PTC/FR1998/001808 (1998).
T. J. Lee, J. H. Seo, M. K. Lee and J. Y. Ryu, Journal of Korea TAPPI,
Gas grafting of fatty acid chloride and recycled fibers,
48(4); 54-61 (2016)
Lee, T. J., Seo, J. H., Lee, M. K., and Ryu, J. Y., Gas grafting of fatty acid chloride and recycled fibers. Journal of Korea TAPPI 48(4):54-61 (2016).
10.7584/JKTAPPI.2016.08.48.4.54T. J. Lee, D. J. Lee, J. H. Seo, K. S. Lee, D. Guerin, P. Martinez and J. Y. Ryu, ACS Sustainable Chemistry & Engineering,
Preventing discoloration of poly (vinyl alcohol)-coated paper hydrophobized by gas grafting with palmitoyl chloride,
6(2); 1702-1707 (2018)
Lee, T. J., Lee, D. J., Seo, J. H., Lee, K. S., Guerin, D., Martinez, P., and Ryu, J. Y., Preventing discoloration of poly (vinyl alcohol)-coated paper hydrophobized by gas grafting with palmitoyl chloride, ACS Sustainable Chemistry & Engineering 6(2):1702-1707 (2018).
10.1021/acssuschemeng.7b02925J. H. Seo, T. J. Lee, K. S. Lee, D. J. Lee, M. K. Lee and J. Y. Ryu, Journal of Korea TAPPI,
Effect of fluff pulp characteristics on the efficiency of gas grafting by fatty acid chloride,
48(5); 5-12 (2016)
Seo, J. H., Lee, T. J., Lee, K. S., Lee, D. J., Lee, M. K., and Ryu, J. Y., Effect of fluff pulp characteristics on the efficiency of gas grafting by fatty acid chloride, Journal of Korea TAPPI 48(5):5-12 (2016).
10.7584/JKTAPPI.2016.10.48.5.5M. K. Lee, J. Y. Ryu, C. G. Kim, G. S. Lee, J. H. Lee, H. J. Cho, H. J. Kwon and D. Guérin, Korea patent,
Paper sensor with temperature history measurement and its manufacturing method (2017)
Lee, M. K., Ryu, J. Y., Kim, C. G., Lee, G. S., Lee, J. H., Cho, H. J., Kwon, H. J., and Guérin, D., Paper sensor with temperature history measurement and its manufacturing method, Korea patent, 10-1733285 (2017).